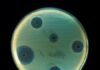
Un nou antibiotic care poate distruge bacteriile rezistente la medicamente, descoperit de oamenii de ştiinţă Antibiotic

Fake news-ul, predat la școlile din Finlanda, iată o veste cu adevărat bună! Dacă în restul lumii, aceasta practică există la ordinea zilei și de cele mai multe ori, este luat ca reprezentând știre veridică, iată că finlandezii au trecut la alt nivel și au ales să îl predea în școli copiilor de școală primară.
Citește și: #SpionulRus îl filează pe Florin Cîțu
De altfel, Finlanda este cunoscută ca fiind țara cu cel mai mare interes pentru combaterea fake news-ului, atitudinea lor pentru astfel de practici fiind una de revoltă și extrem de combativă.
Așadar, încă din clasele primare, în Finlanda copiii sunt învățați să discearnă știrile false, menite să provoace daune anumitor persoane, de cele adevărate. Să spunem că acesta este un fel de lecție de jurnalism, prin care copiii să devină interesați de verificarea surselor înainte de a distribui un anumit fake news.
Pentru ca toate acestea să funcționeze, copiilor li se predau fabule clasice precum „Corbul și Vulpea” de La Fontaine, aducând, astfel, noțiunea de fake news la nivelul vârstei lor.
Însă și la alte materii, în afara literaturii, se pune accentul pe astfel de practici, așadar, la matematică, spre exemplu, copiilor li se arată cam cât de ușor poți manipula statisticile, pe când la orele de artă li se demonstrează ușurința cu care poți distorsiona mesajul trimis prin imagine.
Nici orele de istorie nu scapă combaterii fake news-ului, întrucât aici se plusează pe campaniile de propagandă derulate de-a lungul timpului.
Citește și: Violeta Alexandru acuză PSD de FAKE NEWS
„Obiectivul este acela de a avea cetateni si alegatori activi si responsabili.Gandirea critica, verificarea informatiilor, interpretarea si evaluarea tuturor informatiilor pe care le primesti, de oriunde apar, sunt cruciale. Am facut din acest lucru o parte centrala a materiei, pentru toate disciplinele”, spune Kivinen, directorul unei școli finlandeze.